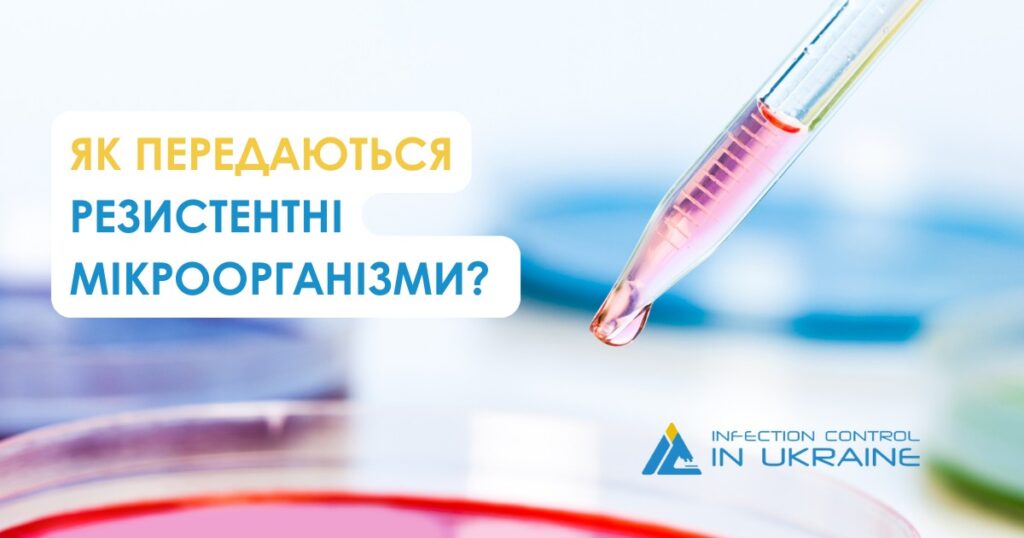

Стійкість до антибіотиків – одна з найбільш глобальних проблем людства нашого часу.
Що більш обізнаним є суспільство стосовно цієї проблеми, то більшими стають можливості успішно протистояти цьому виклику.
► Як же поширюються мікроорганізми, стійкі до антибіотиків?
Стійкі до антибіотиків мікроби можуть поширюватися між людьми з симптомами інфекції та без них. Залежно від виду мікроба, інфекція може передаватися людям різними шляхами:
![]() Через тісний контакт (прямий чи опосередкований) з людиною, яка є носієм стійких мікробів – наприклад, це може статися, коли медичні працівники переходять від одного пацієнта до іншого, не помивши рук.
Через тісний контакт (прямий чи опосередкований) з людиною, яка є носієм стійких мікробів – наприклад, це може статися, коли медичні працівники переходять від одного пацієнта до іншого, не помивши рук.
![]() Через повітря – наприклад, бактерії туберкульозу можуть потрапити в повітря, коли людина з туберкульозом легенів або горла кашляє, розмовляє або співає.
Через повітря – наприклад, бактерії туберкульозу можуть потрапити в повітря, коли людина з туберкульозом легенів або горла кашляє, розмовляє або співає.
![]() Через забруднену воду, яка може включати каналізаційні системи або лікарняний водопровід.
Через забруднену воду, яка може включати каналізаційні системи або лікарняний водопровід.
![]() Через контакт із забрудненими поверхнями, такими як бильця лікарняних ліжок, кухонні прилавки, спільне обладнання (наприклад, обладнання для спільного користування, яке використовується в лікарнях).
Через контакт із забрудненими поверхнями, такими як бильця лікарняних ліжок, кухонні прилавки, спільне обладнання (наприклад, обладнання для спільного користування, яке використовується в лікарнях).
![]() Через тварин – наприклад, вживання забрудненої їжі або дотик до тварин, які є носіями резистентних мікроорганізмів.
Через тварин – наприклад, вживання забрудненої їжі або дотик до тварин, які є носіями резистентних мікроорганізмів.
![]() Статевий контакт з людиною, яка є носієм резистентних мікроорганізмів (наприклад, N. gonorrhoeae або Shigella).
Статевий контакт з людиною, яка є носієм резистентних мікроорганізмів (наприклад, N. gonorrhoeae або Shigella).
Захищайте себе та свою сім’ю! Будьте обізнані щодо АМР!
Джерело:
https://www.cdc.gov/antimicrobial…/data-research/threats